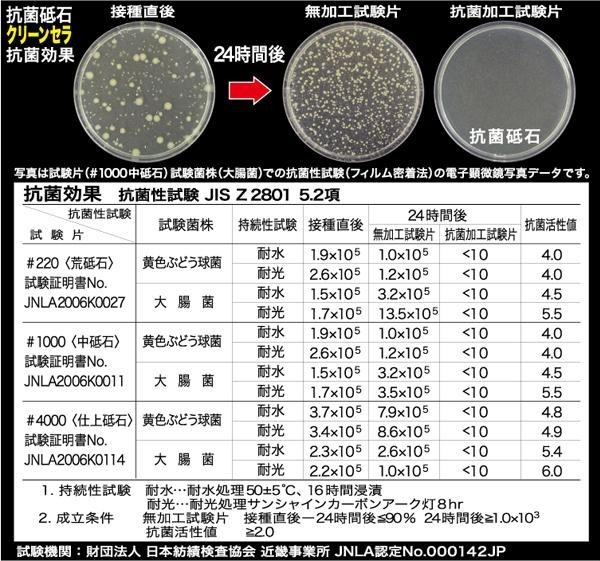

| 【ご注意】 ●安定した台の上でお使いください。不安定な場所での使用はしないでください。包丁を研ぐ時は危険ですので充分注意して研いでください。 ●砥石は割れ易いものです。砥石をぶつけたり落としたりしないでください。 ●幼児の手の届かない所に保管してください。 ●砥石を長時間水に浸けたままにしないでください。 |
 |
|
 |
| SIAA認定のJIS抗菌に適合した抗菌砥石です。 |
| サイズ | 砥石サイズ:205×75×50mm 個装サイズ:22×9×6cm |
| 重量 | 約1460g 個装重量:1540g |
| 素材・材質 | 緑色炭化ケイ素 |
| 仕様 | 粒度:220(荒研ぎ用) |
| 製造国 | 日本 |
| 抗菌加工砥石!! |

|
SIAA認定のJIS抗菌に適合した抗菌砥石です。 |